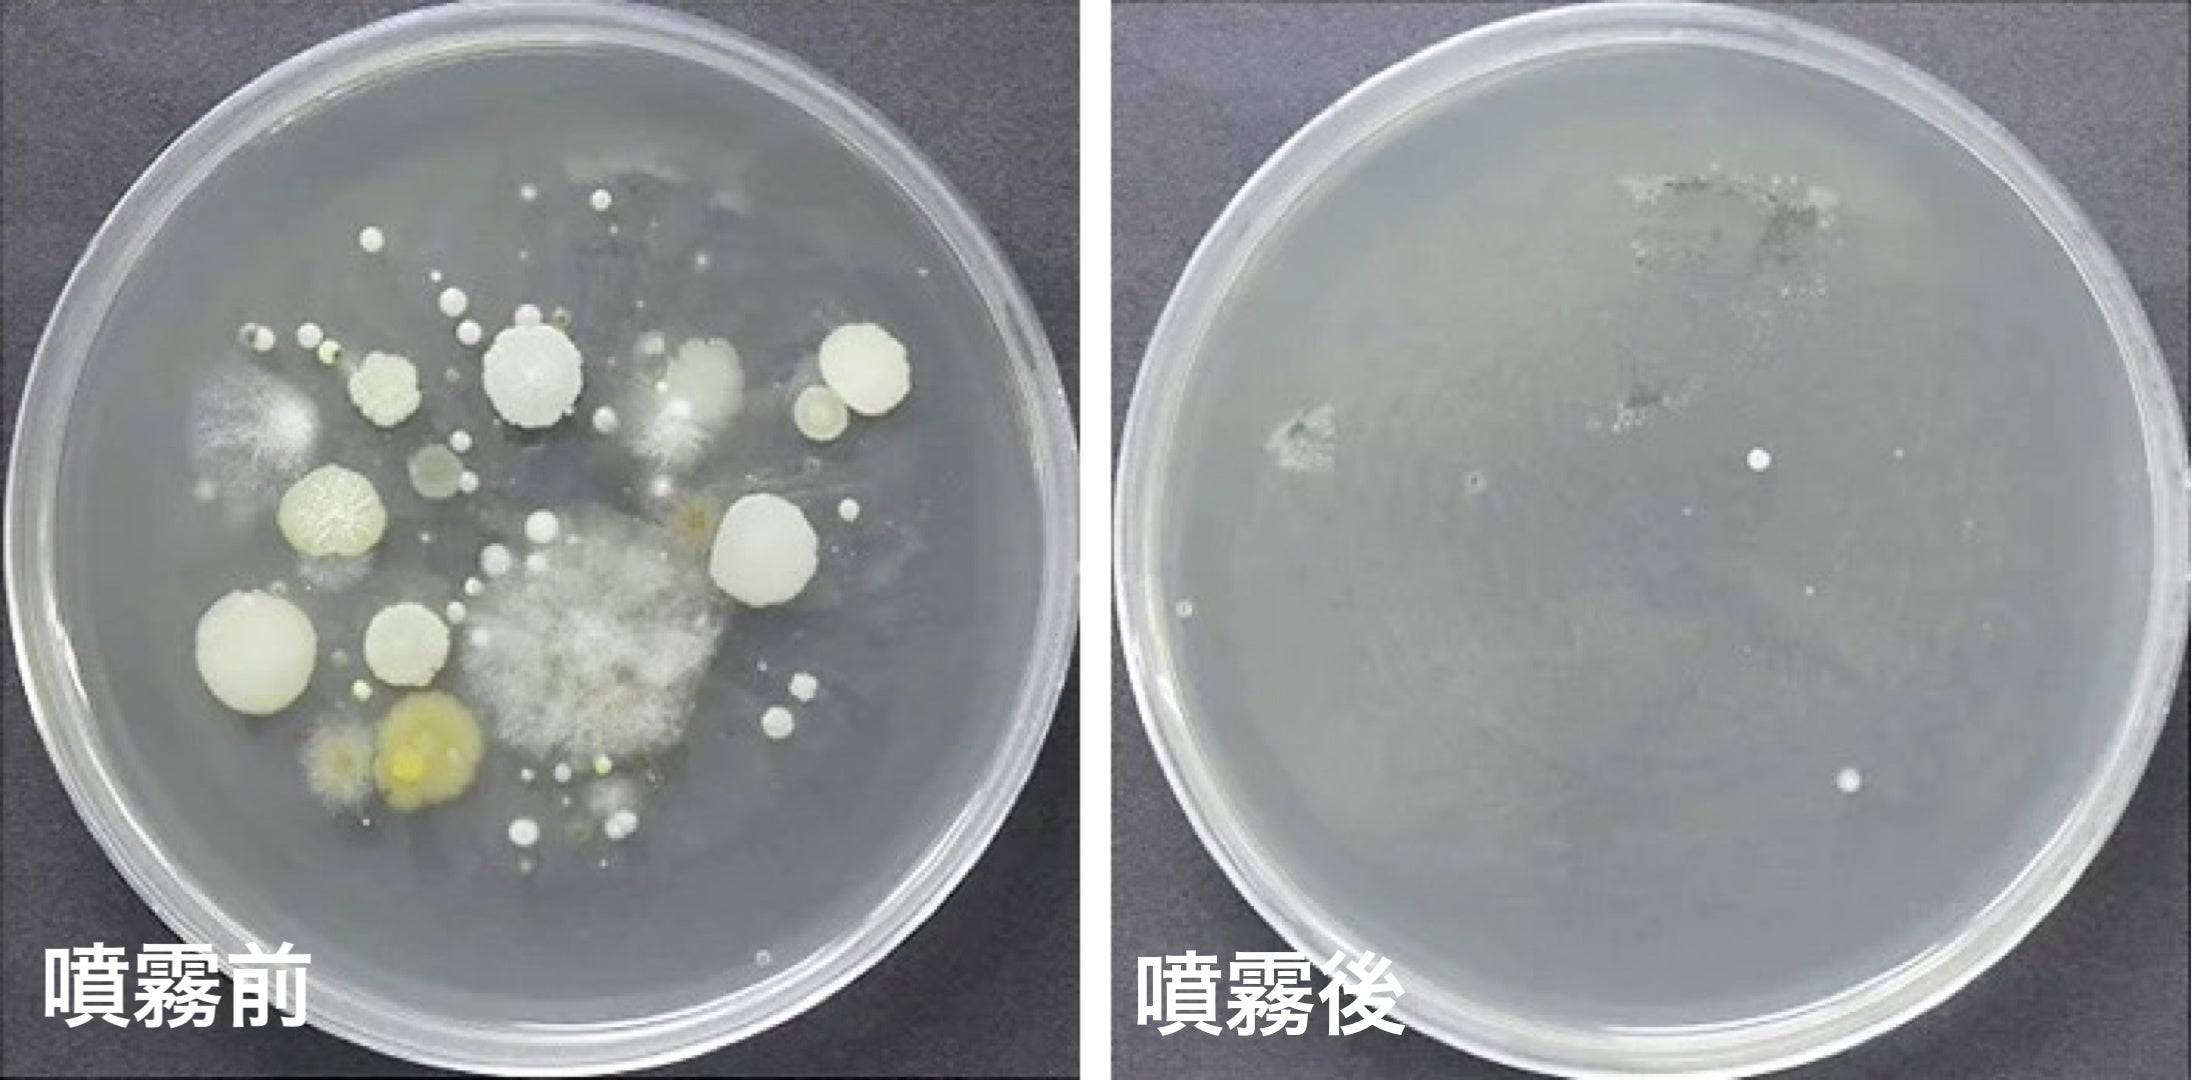
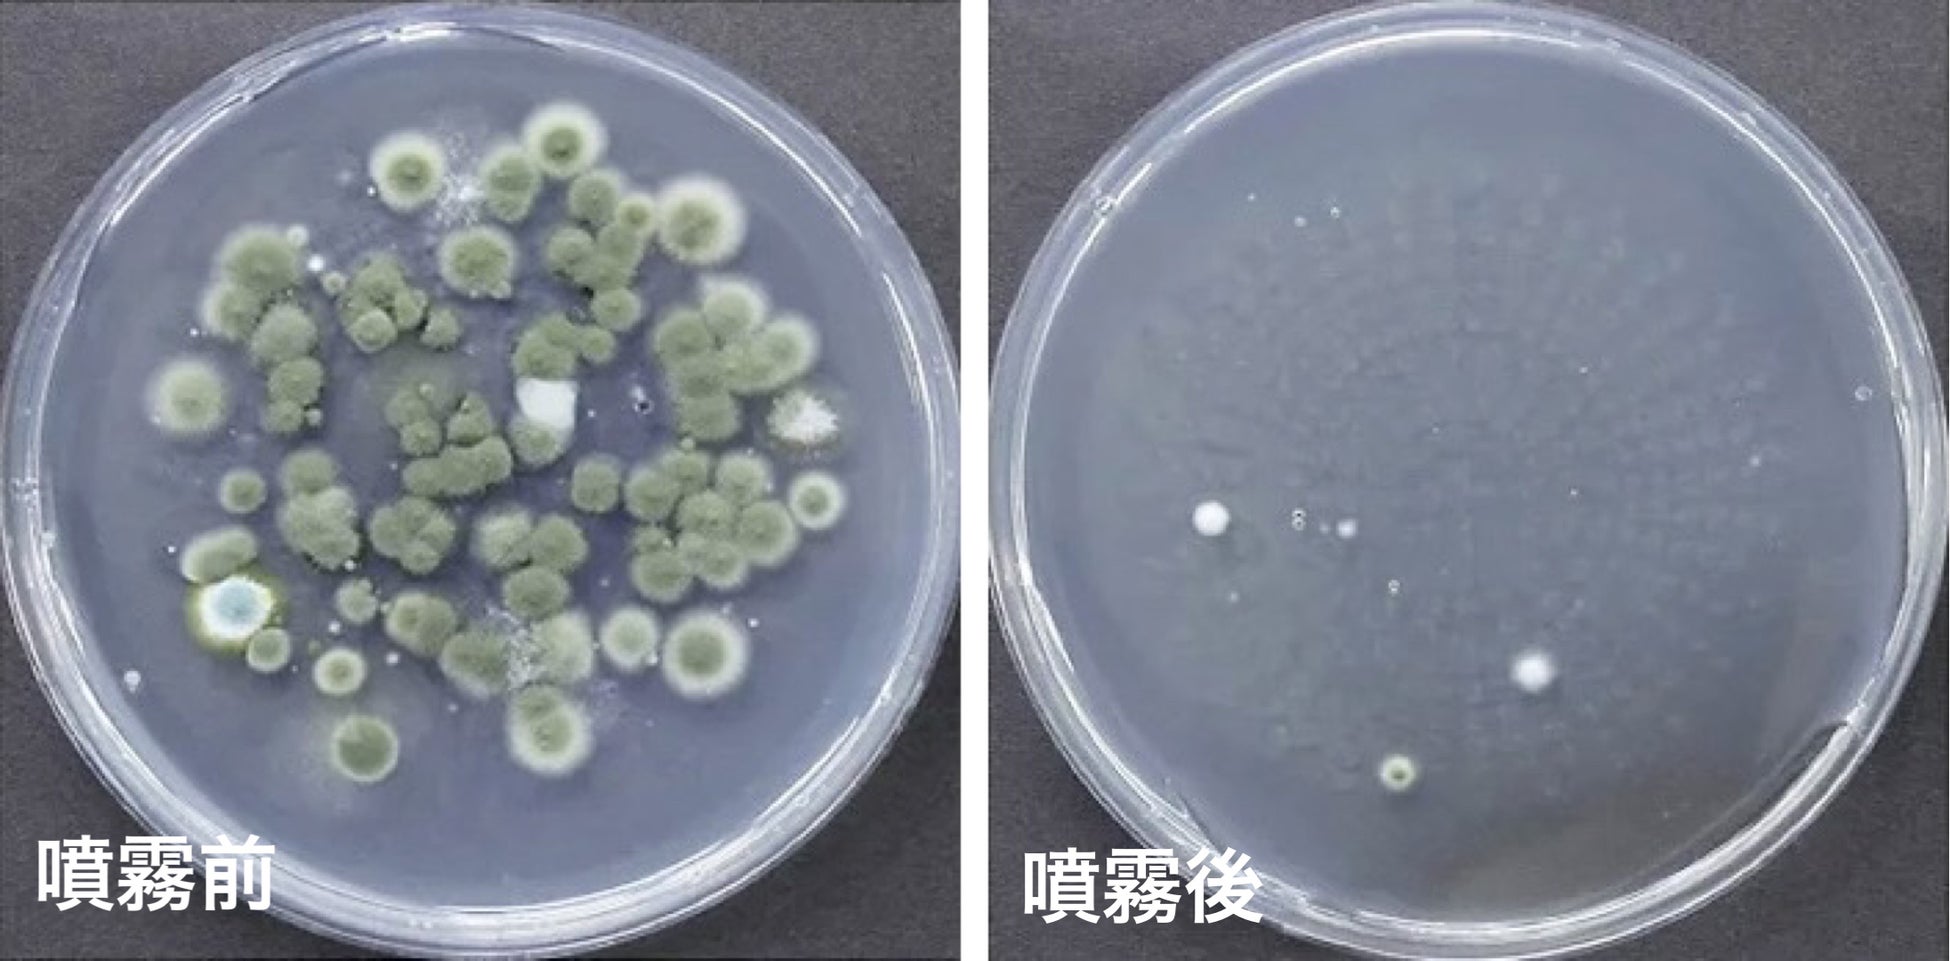

神奈川県お掃除専門店「ハウスエイト」コロナウイルス対策、天然由来の安心・安全な除菌サービス開始
株式会社myconnect(本社:神奈川県藤沢市/代表取締役社長:三宅崇文)が運営しているお掃除専門店のハウスエイト

http://www.house888.biz/jokin.html
【除菌で日々の安心をサポート】
弊社の除菌サービスにはこのようなメリットがあります。
化学薬品不使用の100%天然由来の安全な除菌剤を使用
一般の方では難しい空間の除菌・消臭まで行える
プロの技術ですみずみまで徹底除菌・抗菌
除菌だけでなく抗菌や防カビ、消臭、防虫効果もある除菌剤
除菌後の抗菌効果が長持ちします
広さに応じて選べる価格設定なので、無駄の少ない低価格です。
新型コロナウイルスが猛威を振るっている昨今では、身の回りのものから手指まで小まめに除菌することが大切です。また、細菌やウイルスは常に身の回りに生息しています。そのため、一度だけウイルス対策で除菌をしても、またすぐに付着してしまうのが現状です。
しかし、ハウスエイトで使用している除菌剤は除菌と同時に抗菌コートを行うことで、ウイルスの不活化効果が続きます。また、定期的にハウスエイトに除菌を依頼していただくことで、忙しくてもクリーンな環境を保つことが可能になります。
しかも実のところご料金は、相場よりも断然低価格で除菌サービスをご提供しております。
ハウスエイトでは、より多くのお客様に継続的にご利用いただくため、ご料金は低価格に設定しております。
もちろん、ここまでご説明したとおり、料金が安いからといって粗悪品の除菌剤を使用したり、作業に手を抜いたりすることは一切ございません。
【除菌サービス料金】

除菌箇所サイズ | サイズの目安 | 金額(税込) |
SSサイズ | 5㎡〜8㎡ 車・トイレ・お風呂 | 8,800円 |
Sサイズ | 15㎡〜20㎡10畳前後の寝室・子供部屋・玄関 | 17,600円 |
Mサイズ | 25㎡〜30㎡16畳〜18畳のリビングなど | 24,200円 |
Lサイズ | 35㎡〜40㎡21畳〜24畳の大きめのリビングなど | 30,800円 |
XLサイズ | 45㎡〜50㎡27畳〜30畳の1階、2階のワンフロア全体 | 39,600円 |
その後 | 10㎡増えるごとに | 4,400円 |
お部屋に浮遊しているウイルスや細菌の除菌作業
よく触るドアノブや家具などの除菌作業
抗菌効果で細菌を不活化効果
その他ご希望箇所の除菌作業
除菌サービスは、店舗や自宅の広さにより料金が変わります。
【使用する除菌剤のこだわり】

ハウスエイトの除菌サービスで使用する除菌剤は、国内の第三者検査機関で検査され効果が確認された、信用のあるmade in Japanの除菌剤で、コロナウイルス(豚感染コロナ)を含め、さまざまな病原体に対する不安を解消できるでしょう。さらに、使用している除菌剤は化学薬品を一切使用していない、100%天然由来成分の除菌剤を使用しているので人や家具、環境への影響が少ないことも大きな特徴です。
小さな子どもやペットへの影響が気になり、除菌剤の使用をためらう方もいらっしゃいます。ハウスエイトで使用している除菌剤は、大人も含めて子どもやペットへの影響が少ないのでご安心ください。
【どこでも施工可能】
アルコールや次亜塩素等化学物質を使用していないので、ご自宅をはじめ店舗、オフィスや車内、公共施設への施工が可能です。
【除菌効果】
一般細菌
コロナウイルス(豚感染コロナウイルス)
黄色ブドウ球菌
大腸菌
サルモネラ菌
真菌
カビ菌
国内第三者検査機関での検査結果で上記のウイルスや細菌が99.99%減少し、また浮遊細菌に関しても96%の減少結果も出ております。また抗菌効果の持続期間は約2ヶ月間。その間は99.99%の不活化効果が発揮いたしますので、安心して毎日を送ることができます。また2ヶ月経ったら抗菌効果がすぐに無くなるわけでなく、徐々に効果が薄れていきます。
【噴霧30分後の浮遊細菌減少結果】
【噴霧30分後の浮遊真菌減少結果】
【空間除菌もすることが可能】

ハウスエイトの除菌サービスは、専用機材で除菌剤をナノレベル粒子にし、人の手が届かない場所やソファー・エアコン、空調のダクト等の除菌はもちろん、空中に浮遊しているウイルスや菌まで除菌を行います。また施工後の匂いは天然由来成分の香りでまるで、森林浴のようなスッキリとした空間にいたします。
【定期除菌は店舗ブランディングにも繋がります】

店舗運営者の方々は日々、コロナウイルス対策で、店内の除菌を徹底しているかと思います。我々プロのハウスクリーニング業者に定期除菌を依頼していただくことで、「プロによる除菌をしている」ということが、店舗ブランディングにも繋がります。
安心して店舗を利用できなければ、どのように素晴らしいサービスを提供していてもお客様はご来店されません。店舗サービスや提供商品の問題ではなく、「除菌に不安が残る」という理由で来店されないのは、店舗運営者としても複雑な気持ちになるのではないでしょうか。
また、除菌をしようにもスタッフの人数や時間的な問題で、十分に除菌ができないケースもあります。さらに、除菌ができているつもりでも、不十分な場合もあるでしょう。お掃除のプロであれば、見落としやすいポイントも把握しているため、店内すみずみまで除菌を安心してお任せいただけるのではないでしょうか。
ハウスエイトでは除菌サービスをご利用いただけたお客様に除菌施工ステッカーをプレゼントしております。
このステッカーをお客様の目に止まる所に設置して頂くことで、除菌をしっかりなされている店舗と認識を持っていただきやすくなります。
【ハウスエイトの特徴】
ハウスエイトは神奈川県全域でハウスクリーニングやエアコンクリーニングなどの家や店舗のお掃除サービスを提供している会社です。
お掃除サービスはもちろんのことお客様が不快にならないようマナーや服装にも力を入れております。また使用する洗剤にもこだわりを持ち環境や人に配慮したエコ洗剤を中心に使用しております。
ハウスクリーニング部門地域口コミランキングサイトで1位(令和2年5月19日現在)をいただき各メディアにも取り上げられ、掃除のポイントを解説したり、さまざまな実績がございますので、安心してご依頼いただけます。また損害保険に加入しておりますので、作業時に万一お客様の家財や床、壁などを傷つけても、確実に保証させていただいております。
安心安全・親切丁寧・高い技術で納得できる対応を心がけておりますので、お気軽にご相談ください。
【会社概要】
運営会社:株式会社myconnect
名称:ハウスエイト
代表取締役社長 三宅 崇文
所在地 〒251-0043 神奈川県藤沢市辻堂本町1-9-8
設立 平成26年8月1日
公式サイト:http://www.house888.biz/
エアコンクリーニング:https://www.house888.biz/aircon.html
事業内容:ハウスクリーニング、エアコンクリーニング、オフィス・店舗の清掃サービス、内装用建築資材・住宅設備用品の販売、取付工事及びコーティング業務、リフォーム工事の設計、施工及び管理、家事代行サービス、前各号に附帯する一切の業務
対応エリア:【神奈川県】
川崎地区、横須賀三浦地区、県央地区、湘南地区、足柄上地区、西湘地区、川崎市、横須賀市、鎌倉市、逗子市、三浦市、相模原市、厚木市、大和市、海老名市、座間市、綾瀬市、平塚市、藤沢市、茅ヶ崎市、秦野市、伊勢原市、南足柄市、小田原市、大磯町、二宮町
【横浜地区】
横浜市青葉区、旭区、泉区、磯子区、神奈川区、金沢区、港北区、港南区、都筑区、栄区、保土ヶ谷区、緑区、中区、西区、北区、南区、瀬谷区、鶴見区、戸塚区
【川崎地区】
川崎市川崎区、幸区、中原区、高津区、宮前区、多摩区、麻生区
【お客様からのお問い合わせ窓口】
お問い合わせフォーム:http://www.house888.biz/contact.html
LINE officialアカウント:https://lin.ee/haIQVuK
Instagram:https://www.instagram.com/hausueito/
Twitter:https://twitter.com/houseeight
このプレスリリースには、メディア関係者向けの情報があります
メディアユーザー登録を行うと、企業担当者の連絡先や、イベント・記者会見の情報など様々な特記情報を閲覧できます。※内容はプレスリリースにより異なります。
すべての画像
